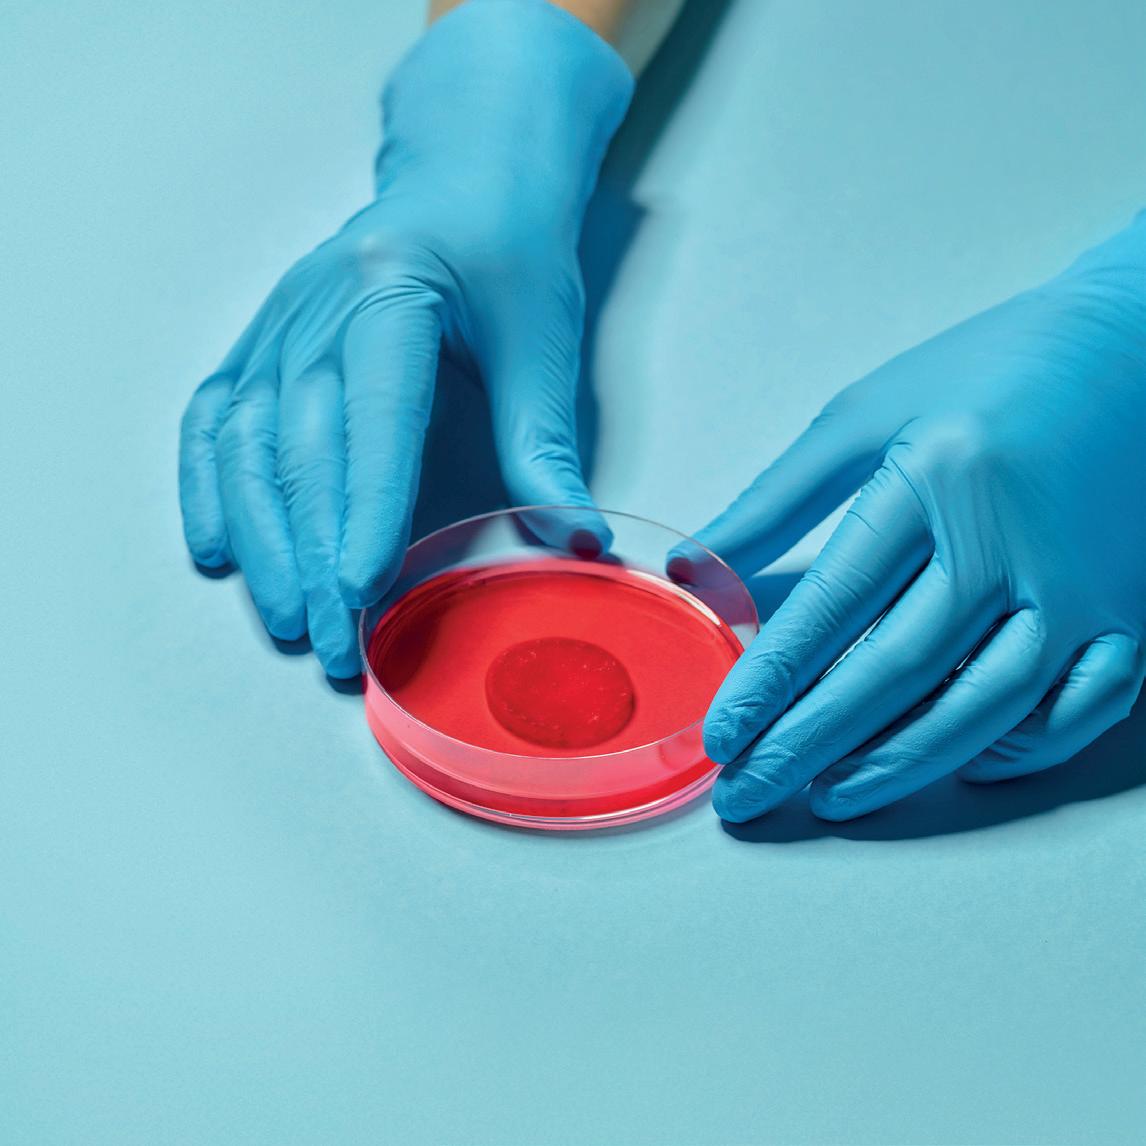

Image provided by BSH
Image provided by BSH
Read more at www.healthawareness.co.ukQ3 2022 | A promotional supplement distributed on behalf of Mediaplanet, which takes sole responsibility for its content “Achieving cardiovascular health for all takes commitment from every sector and many stakeholders, starting with the cardiovascular community.” Fausto Pinto, President, World Heart Federation (WHF) Online “You only need two hands to save a life... and you don’t have to be a medical professional to do it.” Professor Andrew Lockey, President, Resuscitation Council UK Page 04 Cardiovascular Health “Don’t let heart failure stop you from fulfilling your dreams!” For more information visit bsh.org.uk
Peripheral arterial disease is a serious condition that restricts blood supply to the legs and, if left untreated, can cause constant pain, ulceration and even gangrene.
Among the public, there is an awareness that a narrowing of the blood vessels can cause heart attack and/or stroke. But there is much less awareness that a narrowing of the peripheral or outer arteries can restrict blood flow to the leg muscles and tissue, which may have serious consequences if untreated.
What is PAD?
The condition is known as peripheral arterial disease (PAD) and can cause a range of symptoms, explains Mr Neeraj Bhasin, Consultant Vascular Surgeon at the Calderdale and Huddersfield NHS Foundation Trust and Chair-Elect at The Circulation Foundation — a charity that funds, promotes and undertakes research into the causes, prevention and treatment of vascular disease.

“A person with PAD may experience an aching or cramping in the thighs, buttocks or calves after walking a certain distance, which prevents them from going further,” says Mr Bhasin. “Once rested, the pain will stop, and they can continue — but, after a certain distance, it will reoccur.”
Understand your risk
At the most serious end of the spectrum, lack of blood supply can cause critical limb ischemia (CLI), which is associated with constant pain, ulcers and/or gangrene. If left untreated, it may threaten the viability of the leg, risking foot or leg amputation.
Those most at risk of PAD are the over 65s, anyone with a family history of the disease, people with high blood pressure, high cholesterol or diabetes and people who smoke. “It is also associated with other conditions,” says Mr Bhasin. “Those with PAD are at increased risk of coronary heart disease or a narrowing of blood vessels around the heart and blood supply to the brain, increasing the chance of stroke.”

Treatments for high blood pressure and high cholesterol and/or blood thinner medications may be prescribed. For serious cases, invasive therapies and/or surgery may be considered. “If you are experiencing symptoms, seek medical advice as soon as possible,” says Mr Bhasin.
INTERVIEW WITH Mr Neeraj Bhasin
ImageprovidedbyBHF
Find out more at circulationfoundation.org.uk
WRITTEN BY Tony Greenway
Teaching the heart to effectively heal itself with a patch
Regenerative medicine is at the frontier of cardiovascular research. It’s a field of science looking at ways to teach the heart to heal itself.
WRITTEN BY Dr Charmaine Griffiths Chief Executive, British Heart Foundation (BHF)

Our hearts are unique. By the time we are 70, we still have most of the heart cells we were born with. However, because the heart is in continuous motion and never stops pumping blood around the body throughout your lifetime, it doesn’t have the power to repair itself when it gets damaged.
An incurable condition
One of the most common causes of heart damage is heart attack. It is a blockage in an artery supplying the heart muscle, starving it of the oxygen it needs. When this happens, the heart muscle cells can die, and this can lead to heart failure where the heart cannot pump blood as well as it needs to. Heart failure is a debilitating condition that affects almost one million people in the UK; and currently, there is no cure.
Beating heart muscle patches
One of these projects is led by Professor Sanjay Sinha who is running the marathon to raise funds to help power his groundbreaking research. His team at the University of Cambridge are growing real heart tissue in a dish. The result is a hearthealing patch of living heart tissue that contracts in a coordinated way, just like the heart does when it beats.
A revolutionary approach
The team aims to graft the patches onto damaged areas of a person’s heart to repair it, just like a sticking plaster. But the process is not simple. Sanjay’s team uses stem cells — special cells which can become any type of cell in the body — to make the patch.
The BHF are encouraging the nation to get behind Professor Sanjay Sinha to help make the Heart Healing Patch a reality. To find out more visit: gosanjay.bhf.org.uk
This is where regenerative medicine offers hope. The British Heart Foundation (BHF) is the charity of the year for the 2022 TCS London Marathon, and the £3 million raised by our BHF runners will fund nine projects that will accelerate progress in regenerative medicine and find a desperately needed cure for heart failure.
They take stem cells and give them a specific mixture of proteins called growth factors to stimulate them into becoming heart muscle cells. They then put these cells on a “scaffold” and allow them to grow for a couple of weeks, carefully nurturing them into a patch.
The BHF hopes that the inspirational potential of the heart-healing patch will revolutionise the way we care for people with damaged hearts and move away from merely treating the symptoms of heart failure, toward a cure.
Project Manager: Lydia Butler lydia.butler@mediaplanet.com
Business Development Manager: Josie Mason Managing Director: Alex Williams Head of Business Development: Ellie McGregor | Head of Print & Design: Thomas Kent Designer: Aimee Rayment Content Editor: Angelica Hackett O’Toole | Head of Digital: Harvey O’Donnell Paid Media Strategist: Jonni Asfaha Social & Web Editor: Henry Phillips Digital Assistant: Carolina Galbraith Duarte | All images supplied by Gettyimages, unless otherwise specified | Contact information: uk.info@mediaplanet.com or +44 (0) 203 642 0737
Consultant Vascular Surgeon, Calderdale and Huddersfield NHS Foundation Trust and Chair-Elect, The Circulation Foundation
How to recognise the symptoms of peripheral arterial disease and why it’s important
02 MEDIAPLANET A PROMOTIONAL SUPPLEMENT DISTRIBUTED ON BEHALF OF MEDIAPLANET, WHICH TAKES SOLE RESPONSIBILITY FOR ITS CONTENTS READ MORE AT HEALTHAWARENESS.CO.UK
@HealthawarenessUK @MediaplanetUK Please recycle
Paid for by The Circulation Foundation
Committed to creating more inclusive health technology for everyone, every day
AtHuawei, we pride ourselves on delivering technology to keep people connected across the world — that’s why we’re trusted by millions of consumers here in the UK and hundreds of millions more around the world. What’s less well-known is our role as one of the world’s leading healthcare providers — but that’s what we have swiftly become.


In recent years, we have sold hundreds of millions of wearable devices around the world, each equipped with industry-leading healthcare tracking — from simple things like counting your steps to medicalgrade technology that can track your heart rhythm or measure your blood pressure. The reason behind our success is our continued focus and investment in innovation, creating new ways for our users to monitor and manage their health.
Keeping a close watch on your vitals
Our latest innovation — the HUAWEI WATCH D, which received CE medical certification in Europe — tackles a vital area of heart health that many people around the world need to carefully monitor: blood pressure.
Unlike the traditional doctor’s method of pumping up a sleeve around the top of your arm, it uses a similar technique, but around your wrist, delivering an accurate measurement within 30 seconds. This allows people to stay on top of their blood pressure, giving them (and their doctors) regular, accurate readings at the touch of a button. That ease and immediacy, with no calibration required, is something we believe will help to improve quality of life.
The WATCH D, together with our flagship wearable — the WATCH GT 3 Pro — will also launch with ECG analysis, allowing users to test for atrial fibrillation or irregular sinus rhythm. The GT 3 Pro is currently being used by HUAWEI ambassador Sir Mo Farah as he trains for this weekend’s marathon, giving us a chance to see how our technology can track elite performance and help the world’s best athletes reach their peak.

The increasing value of wearables
The launch of our new watch comes at a great time, with sales of health tracking devices increasing, particularly among the over 55s.
A study we conducted recently across multiple markets shows that many people found the
motivation to start using a new health and fitness wearable for the first time during the pandemic. Those that did, encouragingly, were twice as likely to increase their physical activity compared to those that did not.
Our data proves that older generations can enjoy the benefits of new technology and that no one should be left behind.
Inclusive technology for older generations
Surprisingly, results also revealed that while over 55s generally have a lower digital affinity, in three of the six countries surveyed — Germany, France and Italy — these users actively measured more health metrics than younger respondents.
Our data proves that older generations can enjoy the benefits of new technology and that no one should be left behind. Devices that are uniquely created for inclusivity — like the WATCH D — can undoubtedly help people improve their health and wellbeing.
Our partners in research
Our innovations don’t stop there; we’re already making big breakthroughs in health management. We have joined forces with the University of Liverpool and 301 Hospital in China to trial wearables on post-stroke patients. Atrial fibrillation and other factors, such as sleep apnoea and walking pace, will be monitored to see how they affect recovery patterns and the further risk of strokes.
We have also launched three new health research projects: blood sugar monitoring, lung function and health and high-altitude health management — just a glimpse of the breadth of real-world issues that we hope to help people in the near future.
As technology becomes more powerful, the variety of information that people can get from their wearable device is only going to expand and become more useful. We will continue to push those boundaries, finding more ways to give people the technology to live better, healthier lives.
Wearable technology has made great strides in the fitness world over the past few years. Now, it is finding its way to a new audience with diverse healthcare needs.
WRITTEN BY Winston Eavis Marketing Director, Huawei UK
A PROMOTIONAL SUPPLEMENT DISTRIBUTED ON BEHALF OF MEDIAPLANET, WHICH TAKES SOLE RESPONSIBILITY FOR ITS CONTENTS READ MORE AT HEALTHAWARENESS.CO.UK 03MEDIAPLANET
Paid for by Huawei Find out more at consumer.huawei.com/uk
ImageprovidedbyHuawei
Knowing how to respond to a sudden cardiac arrest could be a lifesaver
People need to know the symptoms of sudden cardiac arrest, a potentially deadly condition that affects thousands every year. More importantly, they should know how to respond to it.
Sudden cardiac arrest (SCA) does not discriminate, notes Professor Andrew Lockey, President of Resuscitation Council UK.
INTERVIEW WITH Professor Andrew Lockey President, Resuscitation Council UK

It happens when the heart suddenly stops pumping blood effectively because of a malfunction of the heart’s electrical system, and it can affect anyone — of any age and at any time (although some are at higher risk than others).
Professor Lockey says that it’s important for people to know what to do if someone goes into SCA. It’s the knowledge that could save lives.
Speed is of the essence. Without intervention, the odds of survival decrease about 10% every minute.
Properly identifying SCA
There may be warning signs, such as chest pains, but it often strikes without any warning. Tragically, the survival rate is low.
Sudden cardiac arrest shouldn’t be confused with a heart attack because the symptoms are different. “Someone who is having a heart attack will be awake and talking,” explains Professor Lockey. “Whereas when a person goes into SCA they will be unconscious, not talking, and either not breathing or not breathing normally.”
Each year, in the UK, there are 30,000 out-of-hospital cases.
Why giving chest compressions increases the chances of survival Speed is of the essence. Without intervention, the odds of survival decrease about 10% every minute. Therefore, performing cardiopulmonary resuscitation (CPR) is critical. “You can increase the odds of survival by calling for help, then performing chest compressions,” says Professor Lockey. “This can be as simple as pushing up and down on the chest which buys extra time until an automated external defibrillator (AED) can be used on the patient.”
Education for emergency measures
Visit resus.org.uk or scan the QR code to find out more WRITTEN BY Tony Greenway

AEDs convert the heart back to a normal rhythm and are designed to be used by non-medical professionals. “You only need two hands to save a life,” he adds. “And you don’t have to be a medical professional to do it.”
Resuscitation Council UK wants everyone to have the chance of learning CPR. Its Restart A Heart initiative is teaching schoolchildren CPR and defibrillator awareness. “Over the next 10 years, we will be training a generation of SCA lifesavers,” says Professor Lockey. “Unfortunately, we know that older people — 45 and over — are less aware of SCA and less likely to know about CPR or what a defibrillator is; but it’s vital that they get the message because it could save lives and that is why we have introduced our CPQR campaign to help raise awareness amongst everyone, so you can scan it, learn it, and save a life.”
If you own a defibrillator, please register it at thecircuit.uk so that the ambulance services know its location and can direct local bystanders to use it when they call 999.

Lifesaving made easier
Using a defibrillator can be easier than you think.
Just what you need when faced with a Sudden Cardiac Arrest. Every second counts when responding as survival rates fall by 10% every minute. Quick action by the first person on the scene can make a real difference to the outcome for a victim of SCA.*
Simple fast unique
For more information, please contact aed@stryker.com or scan the QR code
04 MEDIAPLANET A PROMOTIONAL SUPPLEMENT DISTRIBUTED ON BEHALF OF MEDIAPLANET, WHICH TAKES SOLE RESPONSIBILITY FOR ITS CONTENTS READ MORE AT HEALTHAWARENESS.CO.UK
* Cummins RO. 1989. From concept to standard of care? Review of the clinical experience with automated external defibrillators. Annals of Emergency Medicine. 18: 1269–75. CE Class IIb (0123) | Physio-Control, Inc., 11811 Willows Road NE, Redmond, WA, 98052 U.S.A. | Toll free 800 442 1142 | strykeremergencycare.com 07/2020. Copyright © 020 Stryker. GDR 3343034_B
Game-changing keyhole heart surgery reduces patient risk
Leading cardiac surgeon uses a new totally endoscopic approach to repair and fit new heart valves in patients, with several benefits over open heart surgery.
“During open heart surgery, the breastbone is opened, recovery takes three months and patients cannot drive or lift anything heavy for two months,” he says. With that approach, recovery is one month. But with totally endoscopic heart surgery, patients can return to normal daily activity within three weeks.
“Because the chest is not opened, they can breathe faster, mobilise quicker and recover quicker. This technique is a game-changer for patients, reducing the risk of infection and the length of time in hospital,” says Mr Bahrami.
Anew,
minimally invasive, completely endoscopic (keyhole technique) surgery is helping heart patients recover quicker after operations.

Keyhole surgery
Heart valve surgery traditionally involves opening the breastbone and performing the operation through a 20cm incision.
In several UK centres, surgeons offer a less invasive approach with a smaller incision on the patient’s side. But Royal Brompton & Harefield Hospitals (RB&HH) in London is the only UK centre now using a new technique for mitral valve repair and aortic valve replacement.
Higher precision
Consultant cardiac surgeon Mr
A powerful care platform connects medical professionals and patients
Education platforms that disseminate the latest advances in cardiovascular medicine to cardiologists, physicians and healthcare professionals are helping deliver better outcomes for heart patients.
Medical education experts say that while major developments and new data are unveiled at landmark cardiology conferences, a crucial element of the education process is making such breakthroughs more widely available for cardiologists to expand their knowledge on an ongoing basis.
Latest advances
Jelena Spyropoulos believes that better-informed doctors deliver better care for heart patients and empower people to take ownership of their own healthcare and condition.

Spyropoulos is Executive Director for Sales and Strategy at Medscape Education, which disseminates the latest data and advances in cardiology practice from congresses such as the

Toufan Bahrami, who is nationally and internationally recognised in minimally invasive, endoscopic cardiac surgery, explains how the novel approach avoids a large incision or division of the sternum.
The surgeon enters the chest through a tiny cut and spreads the soft tissue. With another incision, he uses a 4K resolution 3D camera that shows the inside of the chest via a high-definition TV monitor in the operating theatre.
Endoscopic instruments are mechanically manipulated, though the surgeon is next to the patient to intervene manually if required.
Quicker recovery
Patients of all ages are eligible for the technique, which has a much faster recovery time.
Compared to other techniques, the length of operations is similar, but hospital stay is reduced by one to two days, and the result looks better because of minimal scarring.
Training and teaching
The approach has training advantages too, as the procedure is displayed on monitors and can be recorded. Mr Bahrami says 4K image quality on the monitor also enables a more accurate assessment of organs.
“To me, this is the future of cardiac surgery; and any patient, whether low risk or high risk, can have this operation,” he adds.
Having conducted many operations, Mr Bahrami trains other surgeons in the technique and works with surgical companies to develop and improve the procedure further.
Find out more at rbhh-specialist care.co.uk

of setting those advances into a meaningful context. “Anybody can go online and read about the latest scientific data released at conferences,” she says. “But we aim to take those findings and putting them into clinical context.”
That involves providing clinicians with a safe environment to apply it in with feedback from leading experts; this is the best way to improve clinical skills.
Connecting physicians
annual European Society of Cardiology conference. Medscape is also a platform that physicians, specialists, nurses and patients can refer to when seeking the latest information.

Indispensable resource Spyropoulos, who has more than 15 years of experience in the medical education sector with a specific focus on cardiovascular disease, says: “Our mission in cardiology is to be an indispensable resource for physicians as they learn about new developments, with the goal of helping them care for their patients.”
“If physicians are not educated or informed about the latest development in cardiology, they will not be able to incorporate those advances into their clinical care.”
She also emphasises the importance
Medscape attends several key cardiovascular conferences, including the European Society of Cardiology, American College of Cardiology and American Heart Association Scientific Sessions.

It holds face-to-face events as well as conference sessions. These are often live-streamed for physicians unable to attend because of travel restrictions or funding limitations.
“We also bring experts in cardiology together to discuss how we can implement the latest advances into our education and ultimately translate them to the bedside.” That allows cardiologists and healthcare professionals to meet, discuss cases or seek advice. A separate arm also provides education for patients.
The platform has 5 million physicians worldwide plus a vast membership of nurses and pharmacists who see it as a global community for staying updated.
INTERVIEW WITH Mr Toufan Bahrami Consultant Cardiac Surgeon
INTERVIEW WITH Jelena Spyropoulos, PhD
Executive Director Sales and Strategy, Medscape Education
WRITTEN BY Mark Nicholls
WRITTEN BY Mark Nicholls
Find out more at medscape.org/ cardiology
Paid for by Medscape
Paid for by Royal Brompton & Harefield Hospitals Specialist Care
A PROMOTIONAL SUPPLEMENT DISTRIBUTED ON BEHALF OF MEDIAPLANET, WHICH TAKES SOLE RESPONSIBILITY FOR ITS CONTENTS READ MORE AT HEALTHAWARENESS.CO.UK 05MEDIAPLANET
ImageprovidededR o yal B ro m p t o n
WRITTEN BY Dr Tony Faranesh Research Scientist, Fitbit

AFib
The power of wearables in the future of heart health

How continuous heart rhythm assessment technology could help smartwatch wearers assess their risk of atrial fibrillation (AFib).
is a common irregular heart rhythm, which can significantly increase a person’s risk of stroke. It occurs when the upper chambers (the atria) beat rapidly and are out of sync with the lower chambers (the ventricles).
People living with AFib face a higher risk of blood clots and heart attacks with a fivefold increase in the risk of stroke.
Understanding the heart condition
AFib is hard to detect as it can be without symptoms and is intermittent. In the UK, AFib impacts around 1.4 million people. This number is likely to be an underestimate as many people are unaware they have the condition and remain undiagnosed.
AFib is more common in older people and those with other medical conditions, such as high blood pressure or type 2 diabetes. However, it can also affect people with no medical conditions, including those who are very physically fit.
Symptoms to look out for
Potential symptoms of AFib may include palpitations, shortness of breath, tiredness and dizziness. Some people are also asymptomatic, especially in the early stages. They may be completely unaware of their irregular heart rhythm and the health problems it can cause.
Some people are also asymptomatic, especially in the early stages.
Studies published by the Lancet and the Stroke Association suggest that as many as 25% of people who have an AFib-related stroke only find out they have the condition after a stroke; others may only find out after a routine medical check-up or when they eventually present with symptoms. Most people living with AFib will progress from having paroxysmal (intermittent) AFib to a persistent or permanent form.
The NHS Long Term Plan, released in 2019, aims to prevent 150,000 strokes, heart attacks and dementia cases over the next ten years.
To complement this, the National CVD Prevention Leadership Forum (CVDSLF) has set targets for the detection and management of AFib, blood pressure and cholesterol (ABC), which are related high-risk conditions.
06 MEDIAPLANET A PROMOTIONAL SUPPLEMENT DISTRIBUTED ON BEHALF OF MEDIAPLANET, WHICH TAKES SOLE RESPONSIBILITY FOR ITS CONTENTS READ MORE AT WWW.HEALTHAWARENESS.CO.UK
Digital progression in heart health – accelerating early detection of AFib with wearables
Our focus is on making the invisible visible with more information about the body including the heart. We want to help people take better control of their own health.
Recent advances in heart rate tracking technology mean some wearables can now assess for signs of AFib in a way that is accessible, convenient and non-intrusive.
“Many in the UK may be living with undiagnosed AFib,” says Dr Shouvik Haldar.

“New irregular heart rhythm tracking technology could help people understand their personal health and make them aware of when they have an irregular heart rhythm that may be AFib. Additionally, having access to their heart health metrics could empower people to get medical advice if needed and hopefully improve lifestyle behaviours. This could help reduce their chances of potentially serious health consequences such as persistent symptoms or even a stroke if they do have AFib.
The term ‘disruptive technology’ is used often these days, but wearable technology to detect AFib is truly disruptive as it challenges the traditional hospital-grade ECG detection tools for AFib detection — patients now come to the hospital with heart rhythm data. We are only just realising the potential capabilities of wearable technology — there is a lot more innovation to come.”
Toomany people are still living with undetected and/or untreated AFib,” Dr Shouvik Haldar, Consultant Cardiologist, comments.
“Early detection of AFib is critical, particularly in those over the age of 65, as timely treatment and management can slow disease progression and reduce symptoms that impact the quality of life and the likelihood of a debilitating stroke.
“One of the criticisms of research assessing the ability of wearables to detect AFib is that there is a disproportionate representation of younger patients who are adept at using digital health devices and are often referred to as the ‘worried well.’ However, there is potential benefit even in this group as detection of AFib should be seen as an early warning, prompting the adoption of healthier lifestyle behaviours.”
Advancing heart technology
Fitbit pioneered the use of heart rate tracking on the wrist with PurePulse technology. Heart rate tracking technology can play a key role in helping detect AFib.
The optimal time to screen for heart rhythm disturbances such
as AFib is when the body is at rest.
Recent advances in heart rate tracking technology mean some wearables can now assess for signs of AFib in a way that is accessible, convenient and non-intrusive. Fitbit’s Irregular Heart Rhythm Notifications has received CE marking and clearance from the FDA.*
Information everywhere you go
The trackers or smartwatches with the feature monitor for signs of an irregular heart rhythm that may be AFib.** Heart rhythm data is collected in the background while users are still or asleep to check for heart rhythm irregularities that may be signs of AFib. This is done by detecting changes in the volume of blood flowing in the wrist through the PPG sensor.
If multiple readings show signs of an irregular heart rhythm, users will get a notification in the app. This enables people to discuss this information with their doctor or healthcare provider to be evaluated further.
With the feature now available in the UK on a range of Fitbit devices, advanced heart health technology is becoming more accessible and convenient.**
Scan the QR code to learn more about how Fitbit can help detect AFib.
**Feature is not available on all Fitbit devices. It is currently available on Charge 5, Charge 4, Luxe, Sense, Sense 2, Versa 2, Versa 3, Versa 4, Inspire 3 and Inspire 2.
 WRITTEN BY Dr Shouvik Haldar Consultant Cardiologist & Electrophysiologist
Spread paid for by Fitbit
*The Irregular Heart Rhythm Notifications feature isn’t designed to detect heart attack, blood clots, stroke or other heart conditions. The Irregular Heart Rhythm Notifications feature is not intended for use by people under 22 years old or with known atrial fibrillation. Results may not be accurate in people who take medication or substances that affect heart rate or blood flow. Only a healthcare professional can diagnose AFib. Smartwatch users are advised not to change medication or any health regimen without talking to their healthcare professional.
WRITTEN BY Dr Shouvik Haldar Consultant Cardiologist & Electrophysiologist
Spread paid for by Fitbit
*The Irregular Heart Rhythm Notifications feature isn’t designed to detect heart attack, blood clots, stroke or other heart conditions. The Irregular Heart Rhythm Notifications feature is not intended for use by people under 22 years old or with known atrial fibrillation. Results may not be accurate in people who take medication or substances that affect heart rate or blood flow. Only a healthcare professional can diagnose AFib. Smartwatch users are advised not to change medication or any health regimen without talking to their healthcare professional.
A PROMOTIONAL SUPPLEMENT DISTRIBUTED ON BEHALF OF MEDIAPLANET, WHICH TAKES SOLE RESPONSIBILITY FOR ITS CONTENTS READ MORE AT WWW.HEALTHAWARENESS.CO.UK 07MEDIAPLANET
“
WRITTEN BY Lynn Mackay-Thomas CEO, British Society for Heart Failure

Finding and treating heart failure to save more lives in the UK
Often hidden in plain sight, heart failure is the endpoint of almost all cardiovascular diseases.
Morecommon than the top four cancers, heart failure is already affecting the lives of nearly 1 million people in the UK, with 200,000 newly diagnosed each year. These numbers are set to grow with the ‘baby boomer’ generation — born between 1946 and 1964 — increasing our ageing population but also because of the Covid-19 pandemic.
Despite this, the growth in clinical understanding and improvement in the management of heart failure over the past 25 years has made it a success story in modern medicine.
Reducing overall rates Keen to build on this momentum, the British Society for Heart Failure (BSH), the professional association for heart failure care in the UK, under the auspices of a campaign called ‘Freedom from Failure –The F Word,’ is determined to change the trajectory of heart failure in the UK and beyond.
Familiarity with symptoms
It is recognised that early diagnosis and referral to specialist care can drastically improve outcomes for those with heart failure.
The ‘Freedom from Failure – The F Word’ campaign has started by encouraging self-recognition of the symptoms of heart failure such as feeling breathless, fatigued and retaining fluid. It also encourages seeking medical advice early.

It is recognised that early diagnosis and referral to specialist care can drastically improve outcomes for those with heart failure.
The BSH is organising a summit of leaders from organisations representing conditions associated with heart failure — such as diabetes, kidney disease and raised blood pressure — to combine efforts and reduce deaths due to heart failure by 25% in the next 25 years.
Earlier elimination
An easy blood test known as ‘NT-proBNP,’ which can be done in general practice, can indicate heart failure if levels are low. Or, if raised, it can indicate the need for further investigation — such as an echocardiogram — to confirm the presence of heart failure.
If heart failure is diagnosed, care provided by a heart failure specialist can help those with the condition live better and longer. In the words of our ‘Freedom from Failure – The F Word’ campaign Ambassador, actorexplorer, Brian Blessed OBE: ‘don’t let heart failure stop you from fulfilling your dreams.’
For more information, please visit: BSH Website: bsh.org.uk
Follow us on social media:
@BSHeartFailure
@BSHeartFailure
britishsociety forheartfailure
BSHfreedom fromfailure
08 MEDIAPLANET A PROMOTIONAL SUPPLEMENT DISTRIBUTED ON BEHALF OF MEDIAPLANET, WHICH TAKES SOLE RESPONSIBILITY FOR ITS CONTENTS READ MORE AT HEALTHAWARENESS.CO.UK
Relieving the pressure in heart failure

help symptoms and prolong life.
For HFpEF, the list of drugs is much shorter, and the pacemakers don’t work as well. Heart transplants and artificial hearts are not realistic options for most patients. Sadly, the prognosis is as bad as it is for cancer.
In addition to these treatments, we are trying to see if taking pressure off the lungs can help symptoms. The FROST-HF trial will see if those with the most severe symptoms of HF may benefit from creating a ‘pressure release valve’ from the left atrium to the right atrium, reducing the pressure on the lungs and making a meaningful difference to sick patients with severe HF. The AFR device is fairly easy to place. It will be interesting to see if it adds to our list of treatments for these highly symptomatic patients.
Heart failure occurs when the heart is not pumping efficiently. Under physical activity, the effects (symptoms) of heart failure are even more pronounced such as shortness of breath.
Sometimes, heart failure symptoms persist, even though doctors and patients are doing their best to manage the condition.
Interatrial shunting
A technique developed in the 1960s known as interatrial shunting can potentially improve symptoms. They make a tiny opening in the wall between the two atria of the heart (interatrial shunt) that acts like a pressure valve. Blood can flow through the opening from the high to the low-pressure side.
Interatrial shunting has been used in many patients with pulmonary hypertension. Doctors have started to use the technique in heart failure patients. It is under investigation to see if interatrial shunting can improve symptoms and outcomes.
Many patients experience reduced symptoms and feel better. But interatrial shunting only works if the shunt remains open. The Atrial Flow Regulator (AFR) is a tiny device that
can be used to keep the interatrial shunt open and control its size. The AFR is implanted using established and safe, minimally invasive techniques performed by specialised doctors (interventional cardiologists).
Publications have shown that the AFR and other devices developed in recent years can be safely implanted and improve symptoms in selective heart failure patients.

The AFR is CE-marked for use in patients with heart failure and is available both on the NHS and in private healthcare.
Varieties of heart failure
Heart failure (HF) comes in two main varieties: 1) Heart failure with reduced Ejection Fraction (HFrEF) — the pump is not squashing down properly and 2) Heart failure with a Preserved Ejection fraction (HFpEF) — it is not the squashing down, but the relaxation after that is the issue.

For HFrEF, many drugs can help. Plus, complex cardiac pacemakers can help re-synchronise the heartbeat,
Studies in the field
There have been several key advances in the care of patients with heart failure over the last 10 years, and treatment can be very effective.
However, for patients that don’t respond and for those with a specific type of heart failure — that is where the heart is stiff and under high pressure — we have few options. These patients can suffer from intractable symptoms of shortness of breath and lethargy, and some need frequent hospitalisation. This is frustrating for patients and their cardiologists and expensive for the NHS.
The concept of interatrial shunting and atrial flow regulation is an exciting prospect which could unload the high pressure in the heart, with the potential to improve symptoms and quality of life.
We already know that it is a safe procedure, and early data supports that it has a positive impact on wellbeing. If it can also reduce hospitalisation rates and improve prognosis, then it could also be highly cost-effective. I look forward to seeing the results of the important large-scale research studies currently being undertaken in the field.


It is under investigation to see if interatrial shunting can improve symptoms and outcomes.
by
Ltd
WRITTEN BY Dr Andrew Flett Consultant Heart Failure Cardiologist, University Hospital Southampton
WRITTEN BY Dr Iqbal Malik Consultant Cardiologist, Hammersmith Hospital and One Welbeck Heart Health
WRITTEN BY Mike Galloway General Manager and Director, Occlutech UK Ltd
A PROMOTIONAL SUPPLEMENT DISTRIBUTED ON BEHALF OF MEDIAPLANET, WHICH TAKES SOLE RESPONSIBILITY FOR ITS CONTENTS READ MORE AT HEALTHAWARENESS.CO.UK 09MEDIAPLANET
©OCCLUTECH_AFR_PPTELEMENTS
Find out more at occlutech.com Paid for
Occlutech UK
Live life to the fullest with the right heart care
We live in immensely stressful times — and in its line of duty, the heart responds magnificently to protect us from the rigours of everyday life.
Heart,
mind and soul are one to me. The heart is our dear friend and minder. Love and compassion make it vibrate with happiness and help us seek out good company.
By that, I mean good music, a love of nature and the countryside and deep peace. Do this, and the heart will respond to your endeavours. Look to the stars: “We are the children of stardust yearning for the stars.”
I am 86 years old (a baby!) and have climbed Everest and reached the magnetic North Pole and completed space training in Star City Moscow and NASA on Reunion Island — all with the aid of a pacemaker, senior physiologists, doctors and nurses. I owe them a debt of gratitude.

Heart failure is treatable, and it is possible to live well with the right care.
I would like to suggest that if you recognise — in yourself or others — any of the symptoms of heart failure such as fighting for breath, fatigue or fluid retention, please seek medical help early. Heart failure is treatable, and it is possible to live well with the right care.
We are all in this together. With the help of our wonderful medical professionals — we will succeed. Be cheerful, be happy and don’t let heart failure stop you from fulfilling your dreams.
BY
Know Your Pulse to know your heart rhythm - it could save your life
Cardiovascular
disease (CVD) is acknowledged as still being one of the main reasons for death, disability and filling a GP’s appointment book. Trudie Lobban MBE, Founder of Arrhythmia Alliance, shares her thoughts on how we, as a society, can help ourselves through lifestyle changes and how the NHS can help us through today’s technology of remote monitoring.

What is remote cardiac monitoring?
This is when information from a patient’s implantable device is sent directly to their doctor. Patient remote monitoring can provide care and support to patients wherever they are, whether in the depth of the countryside or a high-rise flat in a city. Patients who cannot travel can still be connected to their consultant. There is also the bonus of reducing those muchdiscussed waiting lists.
the answer is likely to be – yes! Exercise and general physical activity like gardening and walking, or even hoovering, are excellent ways to prevent further deterioration of your condition, especially as so many of us become less active as we get older.
Keeping your blood pressure under control and knowing your pulse will help protect you from atrial fibrillation which, if not recognised, can lead to an AF-related stroke: www.knowyourpulse.org
Patients who cannot travel can still be connected to their consultant.
Still no definitive diagnosis due to infrequent symptoms? The insertable cardiac monitor (ICM) will monitor your episodes. These will be forwarded to the hospital for assessment immediately. Once a diagnosis is made, a pacemaker or an Implantable Cardiac Defibrillator (ICD) may be advised to manage your condition and protect you from future episodes. These can also be remotely monitored and will save unnecessary hospital visits.
Lifestyle changes and safety
It is always advisable to chat with your GP first, but
Early prevention Prevention is better than cure, and if a family member or close friend has experience with remote monitoring for a condition, then my best advice is to learn from this.
Never assume that you will not be at risk of cardiovascular disease. Worrying symptoms should be shared with your GP. Try to eat fresh vegetables and avoid ready-made meals. Be aware of your weight and the danger of smoking!
When should we seek medical advice, and what can we do to manage our own heart health?
10 MEDIAPLANET A PROMOTIONAL SUPPLEMENT DISTRIBUTED ON BEHALF OF MEDIAPLANET, WHICH TAKES SOLE RESPONSIBILITY FOR ITS CONTENTS READ MORE AT HEALTHAWARENESS.CO.UK
WRITTEN BY Trudie Lobban MBE Founder & Trustee –Arrhythmia Alliance and Founder & CEO AF Association
WRITTEN
Brian Blessed British Society for Heart Failure’s F Word Campaign Arrhythmia Alliance has a patient information booklet on remote monitoring and a helpline if you have a particular concern – 01789 867 501.

I would like to suggest that if you recognise — in yourself or others — any of the symptoms of heart failure such as fighting for breath, fatigue or fluid retention, please seek medical help early.
~Brian Blessed, British Society for Heart Failure’s F Word
A PROMOTIONAL SUPPLEMENT DISTRIBUTED ON BEHALF OF MEDIAPLANET, WHICH TAKES SOLE RESPONSIBILITY FOR ITS CONTENTS READ MORE AT HEALTHAWARENESS.CO.UK 11MEDIAPLANET
One in five people don’t know how to perform CPR.
How a defibrillator saved my life
Three-time Ryder Cup captain Bernard Gallacher OBE calls for defibrillators to become as common as smoke alarms after one saved him when he suffered a sudden cardiac arrest.
Renowned professional golfer and sudden cardiac arrest survivor Bernard explains “You can be fit, you can go to the gym, you can run, you can play golf, you can play sports, and yet you can still have a sudden cardiac arrest, without warning.”
In 2013, the three-time Ryder Cup captain collapsed, suffering a sudden cardiac arrest as he was about to give an after-dinner speech. If it wasn’t for the quick actions of a member of the audience and the prompt use of an Automated External Defibrillator (AED), he would not be here today to tell his story.
WRITTEN BY Trudie Lobban MBE Founder & Trustee –Arrhythmia

A recent survey undertaken by Arrhythmia Alliance found that:
• More than a third of people do not know if their sports club has an AED.
• One in five people don’t know how to perform CPR.
•
One in three people don’t know where their nearest AED is located.
Although most of those who responded know what an AED is, more than 50% said they don’t know how to use one.
Inspiration to give others the same chance
Bernard and Lesley explain what happened on that terrible day, highlighting the importance of having an AED nearby and the peace of mind that his Implantable Cardiac Device (ICD) has provided.
Not everybody can be saved, but everybody deserves the chance to be saved.
Availability of AED devices
Talking about what happened, the quick actions of others, and the life-saving equipment available, “You know he had everything, he had the best chance ever,” reports Lesley, “not everybody can be saved, but everybody deserves the chance to be saved.”
To increase awareness and understanding, Bernard has shared his story together with his wife Lesley, explaining what happened to him and how he is lucky to have survived when 100,000 people in the UK die each year because of sudden cardiac arrest.
Bernard wanted to make others aware and help save lives, so he became an ambassador with Arrhythmia Alliance to campaign for the importance of easy access to defibrillators in the community, golf clubs, and other sporting facilities. He believes AEDs should be as common as smoke alarms. They should be available to all, and so many more lives would be saved each year.
12 MEDIAPLANET A PROMOTIONAL SUPPLEMENT DISTRIBUTED ON BEHALF OF MEDIAPLANET, WHICH TAKES SOLE RESPONSIBILITY FOR ITS CONTENTS READ MORE AT HEALTHAWARENESS.CO.UK
Alliance and Founder & CEO AF Association
